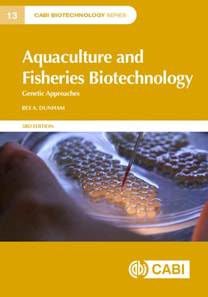
Aquaculture and Fisheries Biotechnology

Aquaculture and Fisheries Biotechnology
Available
The genetic improvement of fish for aquaculture and related fisheries has seen huge advances over recent years. Building upon the previous two editions of Aquaculture and Fisheries Biotechnology: Genetic Approaches, this 3rd edition offers a presentation of traditional selective breeding, modern genetic biotechnology, genomics, gene transfer and gene editing, and the latest developments in genetic...
Read more
E-book
epub
Price
173.25 £
The genetic improvement of fish for aquaculture and related fisheries has seen huge advances over recent years. Building upon the previous two editions of Aquaculture and Fisheries Biotechnology: Genetic Approaches, this 3rd edition offers a presentation of traditional selective breeding, modern genetic biotechnology, genomics, gene transfer and gene editing, and the latest developments in genetic...
Read more
Follow the Author
